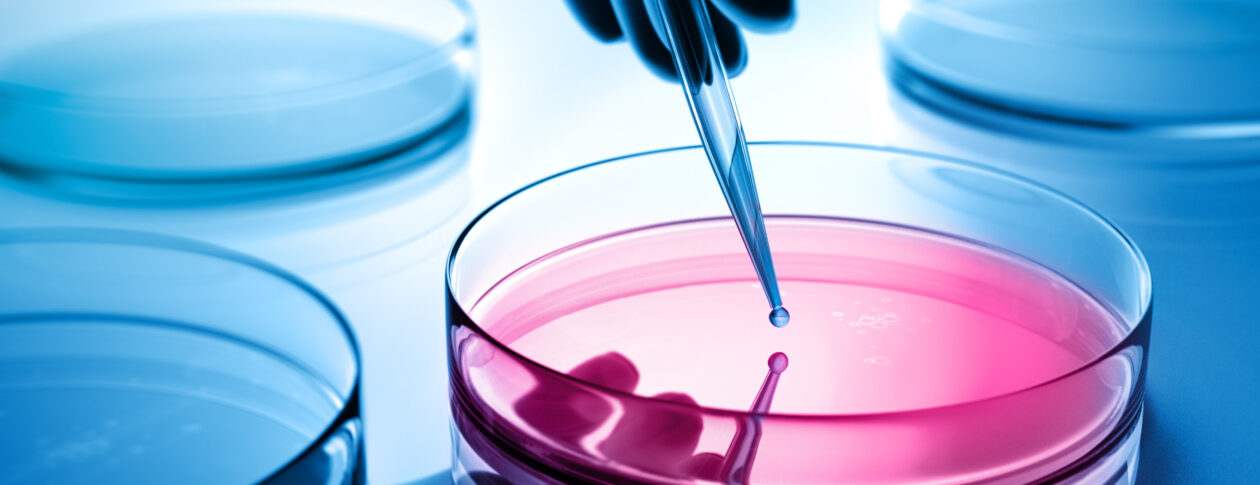
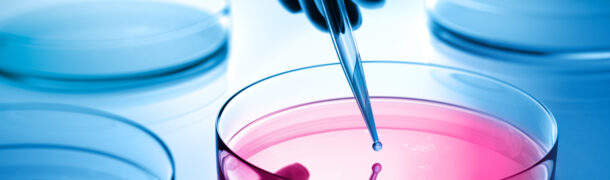

Nos secteurs d’activités
Des solutions sur mesure pour des secteurs exigeants

Pharmaceutique
Les enjeux du secteur sont nombreux :
- Les budgets R&D explosent, soutenus par le passage à l’échelle des essais cliniques et le développement de nouvelles molécules et de nouveaux médicaments
- La consommation de médicaments s’amplifie au rythme du vieillissement de la population et du développement de maladies chroniques
- Les contraintes réglementaires sont renforcées par
- les autorités de santé (FDA, EMA…) qui visent une meilleure sécurité du médicament,
- l’internationalisation des acteurs qui requiert une compréhension des réglementations locales,
- l’essor des transactions de portefeuilles produits qui nécessitent des transferts de licences
- Le besoin d’améliorer la productivité et de digitaliser les processus se renforce
Efor combine une maîtrise des exigences techniques, réglementaires et qualité ainsi qu’une expertise étendue en matière de gestion de projet. Notre proposition de valeur est liée à notre capacité à mêler expertise sectorielle et solutions métiers, permettant de couvrir les projets stratégiques et opérationnels de nos clients que nous accompagnons avec fierté.
Biotech
Organes artificiels, thérapies cellulaires, développement de biomédicaments ou de vaccins… Toutes ces découvertes nécessitent une culture de l’innovation et une maîtrise des requis qualité et réglementaires, domaines d’expertise d’Efor, afin d’accélérer la mise et le maintien sur le marché des produits de nos clients.
Disposant d’un écosystème biotech parmi les plus denses en Europe, la France compte notamment 7 pôles de compétitivité dédiés au secteur auprès de qui le groupe Efor est identifié : Lyon Biopôle, Medicen, Alsace Biovalley, Atlantic Biotherapies, Cancer Bio Santé, Eurobiomed et Nutrition Santé Longévité.

Medtech
Compte tenu des contraintes financières qui pèsent sur les services de santé, la technologie médicale et l’innovation sont clés pour développer de nouveaux outils, de nouvelles façons de soigner les patients et de soulager ainsi les systèmes de santé déjà très sollicités, de les rentabiliser et d’améliorer les résultats pour les patients.
L’industrie des Medtech est également confrontée à des changements importants, que ce soit d’ordre règlementaire, avec la mise en application de nouvelles règlementations rendant plus difficile l’accès au marché, ou d’ordre concurrentiel, rendant ainsi l’accès au marché de plus en plus compétitif.
Avec sa position de leader, Efor possède les références et compétences nécessaires pour accompagner ses clients dans ces nouveaux défis avec pragmatisme et méthode.

Cosmétique
Avec une activité de R&I parmi les plus performantes de l’industrie en nombre de brevets déposés, le secteur prouve sa capacité à anticiper les évolutions et à innover.
La cosmétique poursuit sa stratégie d’amélioration dans un contexte d’exigences réglementaires qui se durcissent et se rapprochent de celles des autres secteurs des Life Sciences.
La naissance d’une véritable conscience écologique chez les consommateurs, les débats sur le parabène, les perturbateurs endocriniens et les ingrédients potentiellement cancérigènes, ont impacté au plus haut point le secteur via une demande pour le « naturel » et le « mieux consommer».
Grâce à une expertise scientifique avérée et une excellente maîtrise des attentes des autorités compétentes, le groupe Efor apporte vision et compétences opérationnelles dans ce secteur en pleine évolution.

Consumer Health
Le marché du consumer health est en plein essor, dynamisé par des consommateurs désireux d’améliorer leur santé au quotidien et soucieux de « mieux vieillir ».
Les enjeux du secteur sont multiples et notamment liés à l’essor de nouvelles technologies permettant de suivre ses données personnelles de santé via des objets connectés. Conscient de ces enjeux, le groupe Efor s’engage dans une démarche d’innovation pour une médecine personnalisée via une plateforme Santé et Bien-être innovante et évolutive appelée Evimeria®. Cette plateforme est un projet d’innovation développé en interne par les équipes Soladis afin de contribuer à la santé de demain en accompagnant au quotidien tout un chacun, quelle que soit son activité. Elle permet d’améliorer sa qualité de vie en facilitant l’adhésion thérapeutique, et en devenant acteur de sa propre santé et de son bien-être.
Habitué des accompagnements techniques, qualité et réglementaires au plus proche des industriels, le groupe Efor a également déployé son expertise auprès des institutionnels et organismes publics afin de devenir un acteur incontournable du secteur.
Pour maintenir notre très haut niveau d’intervention et notre approche conseil chez nos clients, nous sommes convaincus de l’apport des autres secteurs industriels, notamment ceux soumis à de fortes contraintes technologiques.

Global Industries
C’est pourquoi nous consacrons une part de nos activités aux « Global Industries » en accompagnant des acteurs majeurs des industries manufacturières, de l’Energie, des Procédés, du Transport et des Machines Spéciales.
Cette diversité nous permet de nous positionner en tant qu’acteur véritablement différenciant auprès de nos clients, en transposant nos savoir-faire et en leur offrant des solutions innovantes et ajustées à leurs besoins.
In fine, cette approche offre des parcours d’évolution uniques et stimulants à l’ensemble de nos collaborateurs qui ont ainsi l’opportunité de travailler sur des projets variés, de développer de nouvelles compétences et d’étendre leurs horizons professionnels.